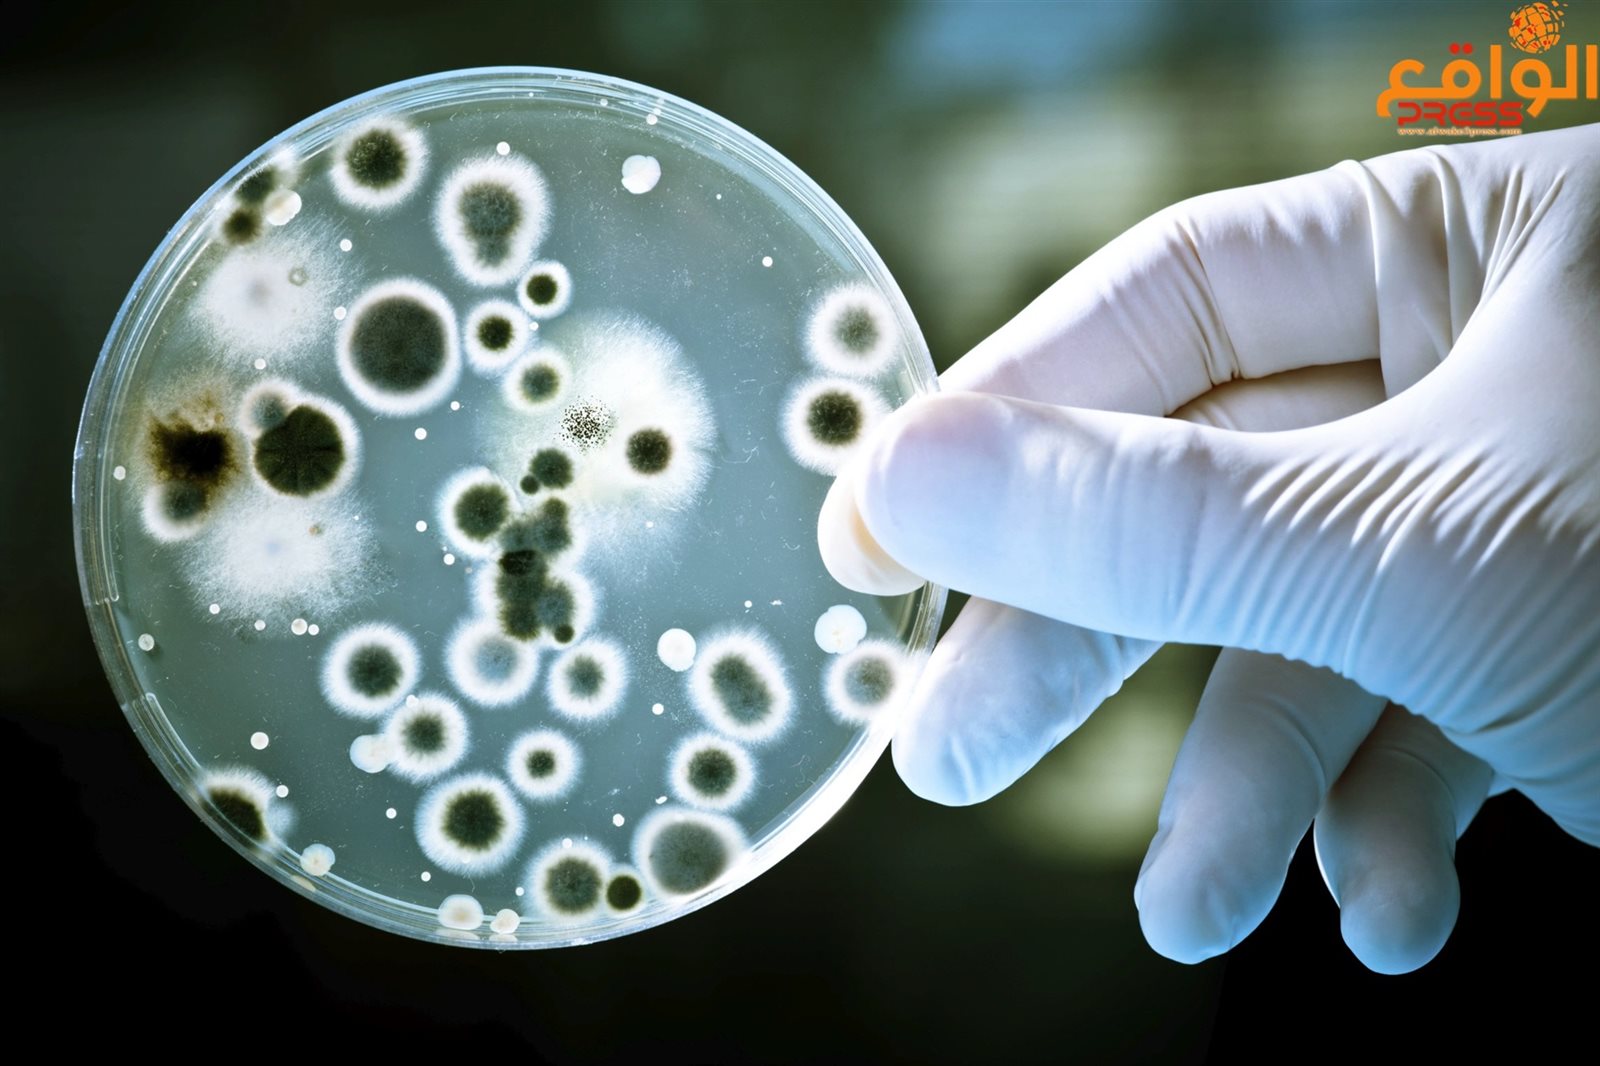

ارتفاع عدد الوفيات من بكتيريا ليستيريا في جنوب أفريقيا إلى 172
قالت حكومة جنوب أفريقيا اليوم الخميس إن عدد الوفيات بسبب تفشي بكتيريا ليستيريا في البلاد تجاوزت مثلي الأرقام التي أحصيت في يناير 2017 لتصل إلى 172 حالة وفاة.
وقال المعهد القومي للأمراض المعدية إنه جرى التأكد من 915 حالة إصابة ببكتيريا ليستيريا منذ يناير من العام الماضي، لترتفع الحالات مقارنة بالأرقام التي صدرت الشهر الماضي وبلغت 61 حالة وفاة و720 حالة تأكدت إصابتها بالمرض.
وقالت الحكومة إن مصدر تفشي المرض لا يزال غير معروف.
وأضافت في بيان أن "المعهد القومي للأمراض المعدية متفائل بأن مصدر تفشي المرض سيجري تحديده، ويحث العامة على عدم الذعر دون داع".
وتنتشر الليستيريا من خلال بكتيريا توجد في التربة والماء والنباتات، وعادة ما يصاب بها البشر من المنتجات الحيوانية والفواكه الطازجة والخضروات.
وقالت وزارة الصحة إن الإصابة بالمرض تتسبب في ظهور أعراض مشابهة للإنفلونزا، ويمكن أن تؤدي للشعور بالغثيان والإصابة بالإسهال وتلويث مجرى الدم والمخ. كما أنها تشكل خطرا أكبر على حديثي الولادة وكبار السن والأمهات الحوامل، إضافة إلى من يعانون من ضعف في نظامهم المناعي.
ويشهد جواتنج، وهو أكبر أقاليم جنوب أفريقيا من حيث عدد السكان، أعلى معدلات الإصابة بالمرض بنسبة 59 % من بين الحالات التي جرى رصدها، ويليه إقليم ويسترن كيب بنسبة 12 % من الإصابات، ثم منطقة كوا-زولو-ناتال بنسبة 7 %.






















